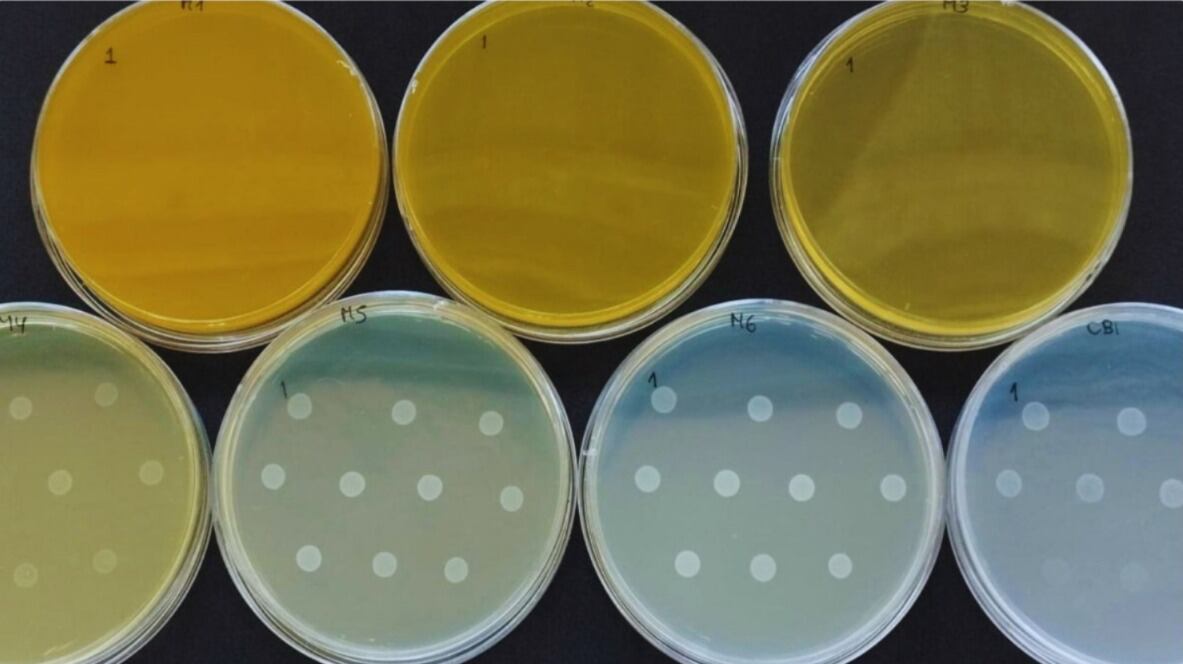

Mientras el mundo busca soluciones al problema creciente de la resistencia a los antimicrobianos, un grupo de investigadores argentinos decidió mirar hacia los compuestos naturales.
En los aceites esenciales del orégano y la canela encontraron una pista prometedora: sustancias capaces de cuidar la salud animal y, al mismo tiempo, mantener la eficacia de los tratamientos del futuro.
El trabajo fue realizado por el Instituto de Patobiología Veterinaria (IPVet) del INTA y del Conicet, en articulación con una empresa privada.
El objetivo era claro: comprobar si el uso prolongado de dos compuestos naturales —el carvacrol, presente en el orégano, y el cinamaldehído, en la canela— podía generar resistencia bacteriana, como sucede con algunos antibióticos tradicionales.

Los ensayos se llevaron adelante en el Laboratorio de Bacteriología General del IPVet y mostraron resultados muy positivos. Los compuestos analizados no generaron clones resistentes ni modificaron la sensibilidad de las bacterias frente a los antibióticos de uso veterinario.
“Los datos sugieren que, incluso tras una exposición prolongada, las bacterias no desarrollaron resistencia a los aceites esenciales”, explicó Johana Domínguez, investigadora del Conicet en el IPVet. Según señaló, estos fitoquímicos pueden incorporarse a la alimentación animal de forma continua, mejorando el rendimiento y garantizando la inocuidad de los productos.
Además, destacó que los aceites esenciales actúan como aliados del bienestar animal: modulan la microbiota intestinal, fortalecen las defensas naturales, mejoran la digestibilidad y funcionan como antioxidantes.
El potencial de estos compuestos también se comprobó en experiencias con pollos de engorde, donde se observaron mejoras en el crecimiento y en la sanidad general de los animales. “La inclusión de cinamaldehído y carvacrol en la dieta de pollos de engorde mejora la ganancia de peso corporal y contribuye a mantener sistemas productivos sostenibles”, indicó Natalia Casanova, investigadora del IPVet.
Para la especialista, estas sustancias naturales, combinadas con probióticos y bacteriófagos, “forman un conjunto de soluciones de bajo impacto ambiental que ayudan a sostener la productividad sin comprometer la eficacia terapéutica futura”.
El proyecto se desarrolló en conjunto con una empresa privada que propuso la hipótesis inicial, bajo un diseño experimental in vitro.
La articulación permitió aprovechar la experiencia y los protocolos del laboratorio del INTA para validar científicamente los resultados.
Desde el equipo investigador destacaron que esta cooperación entre la ciencia y el sector productivo “muestra que es posible generar innovaciones concretas que aporten valor, mejoren la salud animal y fortalezcan la sostenibilidad de los sistemas de producción”.
El estudio abre la puerta a una nueva generación de productos basados en compuestos vegetales, capaces de reemplazar o complementar a los antibióticos tradicionales.
En un escenario donde la resistencia antimicrobiana avanza, la naturaleza vuelve a ofrecer una respuesta: simple, eficaz y al alcance de la ciencia
Fuente: Inta
Luego de relanzar su carrera musical al volverse viral en redes sociales con sus antiguos hits y conectar con nuevas generaciones, ahora, de manera sorprendente, la cantante Nelly Furtado dice adiós a los escenarios, un gesto que coincide o da por terminado un lapso de varios meses en los que la cantante canadiense fue objeto de ataques
Entrelineas
Washington, EE. UU. – El secretario de Estado de Estados Unidos, Marco Rubio, descartó la imposición de aranceles adicionales a Colombia como parte de las sanciones contra el presidente Gustavo Petro, al que acusó de un distanciamiento en la cooperación antinarcóticos. Rubio, en declaraciones a la prensa, aseguró que la Casa Blanca deci
La Torre News
El amor por el horror cósmico ha llevado a adaptar la obra del estadounidense H. P. Lovecraft al videojuego en más de una ocasión. Si bien en el cine ha ocurrido lo mismo, la experimentación que permite el medio interactivo hace que los juegos adquieran mayor presencia en este ámb
3d Juegos
23 de octubre de 2025 Su nombre rara vez aparece en la prensa, pero con frecuencia figura en las agendas de quienes no tienen problemas con el dinero, sino con ellos mismos. Karina Matsueva es la persona a la que uno no acude por inspiración, sino por sanación.
Lado.mx
Elegir entre las mejores barras de sonido requiere mirar más allá del marketing: canales reales, compatibilidad con Dolby Atmos, eARC, tamaño de la sala y cómo verás TV, películas, deportes o juegos.
Lado.mx
Viajar en la era post-pandemia requiere más que entusiasmo: necesitas protección real ante imprevistos médicos. Un seguro de viaje con cobertura COVID se ha convertido en el aliado indispensable para quienes buscan tranquilidad sin sacrificar la aventura.
Lado.mx
PATRICIA BRISEÑOEl magisterio oaxaqueño, adherido a la Coordinadora Nacional de Trabajadores de la Educación (CNTE), se levantó ayer de la mesa de diálogo tripartita con los gobiernos federal y estatal, celebrada en la Ciudad Administrativa Benemérito de las Américas, ante la ausencia de respuestas satisfactorias a sus exigencias.Yenny Arace
Excelsior
ERNESTO MÉNDEZ Y EMMANUEL RINCÓNEn un esfuerzo a contrarreloj por restablecer la normalidad tras los severos deslaves y desbordamientos, en Hidalgo han logrado remover hasta 307 mil 291 metros cúbicos de material que bloqueaba caminosy carreteras.Las labores de limpieza y recuperación, que involucran a 5 mil 023 trabajadores estatales y 239 má
Excelsior
El concurso de Telecinco ha ofrecido la oportunidad a los eliminados de regresar a la pista de baile y merecerse una repesca
Infobae
El libro “Hilando historias, tejiendo esperanza”, presentado este viernes en el Forum Cultural de León, reúne a periodistas, defensoras de DDHH y buscadoras
Periódico Correo
Por Noé Zavaleta/La Opinión de México La promesa de disciplina fiscal se convirtió en letra muerta. El gobierno de la cuarta transformación de Claudia Sheinbaum Pardo pospuso la consolidación fiscal, mantiene ingresos relativamente estables y aumenta el gasto, sobre todo en dos rubros: las transferencias a Pemex Sin embargo, desde 2019,
Sol Yucatán
Luis RamírezLa carrera del Gran Premio de México 2025 podría dejar un nuevo líder del campeonato de pilotos de la Fórmula 1 e intensificar la contienda luego de que Lando Norris se aseguró la pole position, esto mientras Max Verstappen y Oscar Piastri, sus dos rivales por la corona individual, quedaron fuera de las dos primeras filas de parti
Excelsior
Dice la leyenda que aquel que sea capaz de tomar primero la curva uno en el GP de México, podrá ganar la carrera. ¿Quién será ese piloto?
ESPNdeportes.com
Ricardo Peláez rompe en llanto tras recordar a Manuel Lapuente El analista de ESPN no pudo contener el llanto al recordar al entrenador amartinezDom, 26/10/2025 - 07:50
Record
Refrescar 2 horas hasta el comienzo (Crédito de la imagen: Getty Images- Matthew Ashton) En poco menos de dos horas, 3 emocionantes juegos en Gameweek 2 de la Premier League comienzan. Los lobos viajan al estadio de vitalidad para enfrentarse a las cerezas, Brentford recibe Aston Villa en el GTech y los recién llegados de …
Mas Cipolleti
Arturo López / AFPEl Manchester City volvió a las andadas, luego de reincidir en los errores defensivos que le dieron dolores de cabeza en la temporada pasada. El Tottenham los aprovechó para vencerlos 0-2 en el Etihad Stadium, duelo de la jornada 2 de la Premier League.- TE PUEDE INTERESAR: Así "vacunó" Gilberto Mora a ChivasLos “
Excelsior
El Inter de Milán reaccionó luego de dos derrotas sucesivas en la Serie A italiana al derrotar 2-1 al Sassuolo este domingo en la cuarta fecha. Sorprendido en casa ante Udinese (2-1) y tras la remontada sufrida ante la Juventus en Turín (4-3), el Inter y su nuevo entrenador, Cristian Chivu, sabían que su actuación […]La entrada Inter de
Versus.com.py
Enrique LópezLa Roma atraviesa un inicio de temporada prometedor en la Serie A. El conjunto capitalino derrotó 2-0 al Hellas Verona en el estadio Olímpico durante la quinta jornada del campeonato italiano, resultado que lo catapulta al segundo puesto de la clasificación con 12 puntos de 15 posibles.TAMBIÉN PUEDES LEER: Roma triunfa en el derb
Excelsior
¿Cuándo y dónde ver Genoa vs Lazio de la Serie A? Johan Vásquez entra en acción en el cierre de la quinta jornada rperezDom, 28/09/2025 - 19:43
Record
Últimas noticias
Rodada nocturna inundó y rompió récord sobre Reforma: 190 mil personas
El eco de la esperanza en tiempos de barbarie
Estos son los hábitos nocturnos que te ayudarán a dormir mejor
Frente frío 10 y onda tropical 39 dejarán lluvias y bajas temperaturas
Gobernador de California analiza postularse a la presidencia en 2028
“Preferiría morir”: Guillermo del Toro arremete contra el uso de inteligencia artificial generativa
Acá podrá ver EN VIVO el clásico paisa entre Nacional y Medellín
desafíos del cliente
Corazones 3 – 1 Celta
Fuentes: Apple está trabajando en una cámara de vapor para el próximo iPad Pro en 2027 y planea comenzar a vender anuncios en su aplicación Mapas el próximo año (Mark Gurman/Bloomberg)
Cómo ver la temporada 7 de Love Island Australia online gratis desde cualquier lugar
Patrick Mahomes y su esposa Brittany ayudan a recaudar 1,5 millones de dólares en una gala benéfica en fotos
La idea rusa de un intercambio de cereales BRICS para contrarrestar la CME cobra impulso
Kuznechik, el camello que acompañó a la división de fusileros del Ejército Rojo durante la Segunda Guerra Mundial
La historia insólita de un jefe y un empleado que pidió trabajar en casa porque no podía caminar